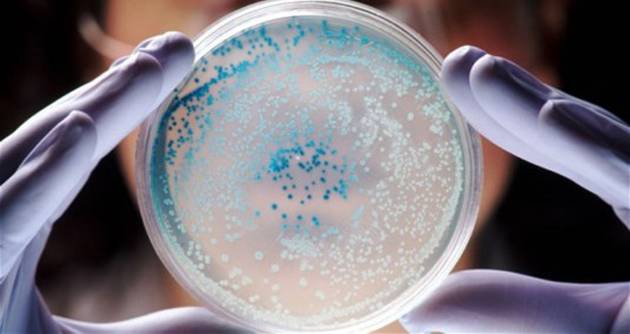
Дознајте ја разликата помеѓу вирус и бактерија

Иако навидум слични, вирусите и бактериите се различни како локомотива и слон. Сепак, многумина овие два поима ги мешаат поради тоа се мисли бактериите и вирусите предизвикуваат исти симптоми – болка во грлото, течење нос, главоболка, повраќање, воспалителни процеси, зголемена телесна температура, грчеви и сл., а неретко се пренесуваат на ист или сличен начин – по пат на плунка или слуз, преку храна, вода, животни и сл. Бактериите и вирусите се нарекуваат уште и микроби и можат да бидат подеднакво смртоносни.
Можеби по овие факти нема да ви биде важно дали имате вирусно или бактериско воспаление, но она што е важно да се знае од денешната перспектива на лечење со лекови е, дека бактериските воспаленија можат да се лечат со антибиотици, додека пак против вирусните нема лекови, туку постојат вакцини, а тука е и вашиот имунитет кој ќе ви помогне да се изборите со вирусите.
Разликата меѓу бактериите и вирусите
Иако и вирусите и бактериите се микроби, сепак тие се неверојатно многу различни. Бактериите се едноставни организми, релативно комплексни. Некои од нив се размножуваат со делба, додека пак други со полово размножување. Тие се најстарите жители на планетата Земја, прилагодени на екстремни услови – студ, топлина, радијација; можат да живеат во живи суштества и надвор од нив, и секако притоа можат да се размножуваат и да хибернираат. Воедно, треба да се спомне дека 99% од бактериите се безопасни, т.е. дури и корисни кога станува збор за нормално функционирање на дигестивниот систем и сл, а „само“ тој еден процент ни задава проблеми и придизвикува болести.
Вирусите пак се најмалиот жив облик на планетата и се помали од бактериите од 10 до 100 пати. Некои научници сметаат дека вирусите не се живи организми, туку се работи за ДНК и РНК информација која се пренесува по „насилен“ пат од една клетка до друга. Вирусите не се едноставни организми како бактериите: тие се бесклеточни организми кои имаат само протеинска обвивка и јадро кое го носи генетскиот ДНК или РНК материјал.
Вирусите пак, за разлика од бактериите, не можат да преживеат надвор од своите домаќини (некој друг организам), бидејќи се размножуваат така што се врзуваат за клетките за својот домаќин. Во поголем дел од случаите, вирусите го инјектираат својот генетски материјал во клетката и ја репрограмираат при што таа станува извор на нови вируси и истата се распрснува и умира. Во некои од случаите, некои вируси ги претвораат здравите клетки во малигни клетки на канцер.
Вирусите, за разлика од бактериите, не се делат на корисни и некорисни, односно добри и лоши, туку тие секогаш предизвикуваат тешки или полесни болести. Кога станува збор за избор на клетките кои ги напаѓаат, вирусите се многу пребирливи. Некои вируси ги напаѓаат само клетките на црниот дроб, некои на респираторниот систем, а некои крвните клетки. Понекогаш се случува вирусите да ги напаѓаат и бактериите.

Како се откриваат?
Во многу случаи кај стандардните настинки и болести на респираторниот систем е тешко да се утврди дали имате вирусна или бактериска инфекција, но за такви иинфекции најчесто не се прават детални испитувања, туку докторот сам проценува каква терапија да препише. Но, кај посериозни здравствени проблеми како на пример воспаление на белите дробови, менингитис или сериозен облик на дијареа, причинителот на проблемот се утврдува со микробилошки испитувања. Во одредени случаи, потребно е да се направи и биопсија на ткивото.
Иако откривањето на антибиотикот е најголемото откритие во историјата на медицината, неговата претерана употреба довела до разни мутации на постоечките бактерии, кои, за жал, со тек на време станале отпорни на некои видови на антибиотиици.
Антибиотиците не делуваат против вирусните заболувања, и смеат да се користат само додека не се утврди вистинскиот избор на болеста, бидејќи тие можат да го нарушат имунитетот со што им се олеснува размножувањето на другите вируси и бактерии.
Лечење на вирусните и бактериските воспаленија
Иако вирусите и бактериите се насекаде, за среќа луѓето не се во целост препуштени на нивната милост и немилост, барем не на сите нив. На почетокот на 20-тиот век произведени се бројни вакцини против опасните вирусни заболувања како што е детската парализа, сипаници и сл. Воедно, произведени се вакцини против грип, хепатисис А и Б, ХПВ итн.
Научниците работат на откривање на лекови против различните вируси, но бидејќи најчесто фармацевтските компании ги откупуваат правата за производство на лековите, може да помине многу време пред одреден лек да дојде на потрошувачкиот пазар.